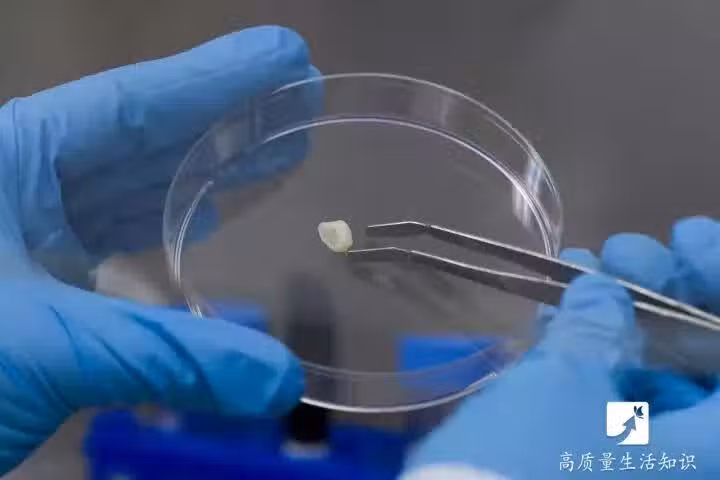

7/7
下一頁
孩子乳牙脫落後不要扔掉!關鍵時刻能「救命」
7/7
中國首家GMP級口腔幹細胞庫已成立。
具體是將乳牙的幹細胞保存在冷凍的液氮中,儲存時間能長達30年,未來可用於治療兒童成長過程中遇到的意外或疾病。
所以對於孩子身體某些遺傳性或先天的疾病,儲存孩子的乳牙是個不錯的選擇,比如先天性心臟病、先天性失明等。
「世界口腔幹細胞之父」施松濤教授特別指出,口腔幹細胞目前最有效的採集源是,兒童的乳牙,和20歲前青少年的恆牙和智齒。
小時候你也是「上排牙齒掉了,就扔到床底下;下排牙齒掉了,就往屋頂上面扔。」嗎?
具體是將乳牙的幹細胞保存在冷凍的液氮中,儲存時間能長達30年,未來可用於治療兒童成長過程中遇到的意外或疾病。
所以對於孩子身體某些遺傳性或先天的疾病,儲存孩子的乳牙是個不錯的選擇,比如先天性心臟病、先天性失明等。
「世界口腔幹細胞之父」施松濤教授特別指出,口腔幹細胞目前最有效的採集源是,兒童的乳牙,和20歲前青少年的恆牙和智齒。
小時候你也是「上排牙齒掉了,就扔到床底下;下排牙齒掉了,就往屋頂上面扔。」嗎?
 幸山輪 • 40K次觀看
幸山輪 • 40K次觀看 幸山輪 • 1K次觀看
幸山輪 • 1K次觀看 喬峰傳 • 4K次觀看
喬峰傳 • 4K次觀看 呂純弘 • 2K次觀看
呂純弘 • 2K次觀看 李雅惠 • 430次觀看
李雅惠 • 430次觀看 幸山輪 • 820次觀看
幸山輪 • 820次觀看 幸山輪 • 340次觀看
幸山輪 • 340次觀看 幸山輪 • 830次觀看
幸山輪 • 830次觀看 老臘肉 • 1K次觀看
老臘肉 • 1K次觀看 李雅惠 • 240次觀看
李雅惠 • 240次觀看 李雅惠 • 210次觀看
李雅惠 • 210次觀看 呂純弘 • 650次觀看
呂純弘 • 650次觀看 李雅惠 • 240次觀看
李雅惠 • 240次觀看 喬峰傳 • 640次觀看
喬峰傳 • 640次觀看 老臘肉 • 4K次觀看
老臘肉 • 4K次觀看 喬峰傳 • 1K次觀看
喬峰傳 • 1K次觀看 奚芝厚 • 290次觀看
奚芝厚 • 290次觀看 許夢可 • 220次觀看
許夢可 • 220次觀看 舒黛葉 • 890次觀看
舒黛葉 • 890次觀看 喬峰傳 • 310次觀看
喬峰傳 • 310次觀看 幸山輪 • 160次觀看
幸山輪 • 160次觀看 喬峰傳 • 2K次觀看
喬峰傳 • 2K次觀看 幸山輪 • 330次觀看
幸山輪 • 330次觀看 呂純弘 • 5K次觀看
呂純弘 • 5K次觀看






















